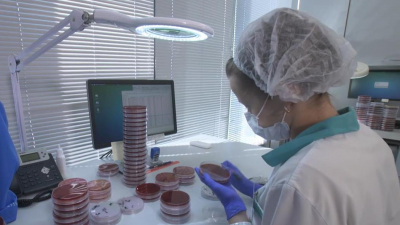
Лаборатория без границ: медицинские технологии из Германии в Петербурге

Наука и технологии

Еврокомиссия оштрафовала Google на 4,35 млрд евро
Европейская комиссия оштрафовала Google на рекордные 4,34 миллиарда евро. Компанию обвиняют в «нарушении антимонопольных правил ЕС» и «незаконных ограничениях».
18 июля 2018 14:31

В Петербурге в преддверии Дня ВМФ заложат корабль противоминной обороны
В Петербурге заложат пятый в серии корабль противоминной обороны проекта 12700. Торжественная церемония на Средне-Невском судостроительном заводе 27 июля, в преддверии Дня ВМФ.
18 июля 2018 13:43

«Яндекс» получил разрешение на разработку российского смартфона
Компания «Яндекс» получила разрешение на разработку смартфона. Об этом пишет ТАСС со ссылкой на материалы Единого реестра нотификаций о характеристиках шифровальных средств и товаров. Документ опубликован на сайте Евразийской экономической комиссии.
12 июля 2018 22:37

Пользователи заподозрили сеть фастфуда в сборе данных банковских карт
Посетители интернет-форума «Пикабу» выяснили новые возможности приложения сети ресторанов быстрого питания «Бургер Кинг».
12 июля 2018 17:01

Эксперты рассказали, почему Марс весит меньше Земли
Ученые объяснили, почему одни планеты превосходят другие по размеру и массе.
11 июля 2018 17:22

Что в гаджете моем, или Как зависит тип смартфона от дохода пользователей
Признак богатства и бедности. Американские исследователи выяснили: в США наличие iPhone - признак хорошего заработка. 70% владельцев техники Apple - состоятельные граждане. А как обстоят дела в России?
10 июля 2018 20:27

Роскосмос организовал самую быструю в истории доставку груза на околоземную орбиту
Госкорпорация Роскосмос впервые провела скоростной запуск грузового корабля «Прогресс». Космический корабль добрался до МКС всего за три часа 40 минут.
10 июля 2018 02:49
Лаборатория без границ: медицинские технологии из Германии в Петербурге
Старейшая лаборатория LADR GmbH MVZ Dr. Kramer & Kollegen в Германии с широкой сетью филиалов по всей Европе в течение уже более чем 10 лет успешно развивается на российском рынке.
9 июля 2018 15:00

Илон Маск проводит тестирование мини-субмарины для спасения детей в Таиланде
Основатель компаний SpaceX и Tesla Илон Маск начал испытывать мини-субмарину, которую он предложил использовать для спасения подростков, заблокированных в пещере в Таиланде.
9 июля 2018 09:38

В Петербурге могут создать новый комплекс тяжелого станкостроения
На базе петербургского «Станкозавода «ТБС» может появиться новый научно-производственный комплекс. Возможности запуска производства обсуждали сегодня на выездном совещании с вице-губернатором Сергеем Мовчаном.
6 июля 2018 17:28

Первый в России циклотрон нового поколения запустили в Петербурге
В медицинском институте имени Березина Сергея презентовали аппарат для производства радиофармпрепаратов.
4 июля 2018 15:46

Красивый деликатес: в Ботаническом саду рассказали о секретах лотоса
Прекрасный съедобный цветок можно увидеть в Ботаническом саду Петербурга.
4 июля 2018 13:41

В Петербурге запустят первый в России циклотрон нового поколения
Сегодня в медицинском институте имени Березина Сергея торжественно запустят первый в России циклотрон нового поколения.
4 июля 2018 08:42

На фестиваль Geek Picnic в Петербург приедет специалист по теории струн Лиза Рэндалл
Всемирно известный специалист по теории струн и физик-теоретик Лиза Рэндалл выступит на фестивале Geek Picnic, который пройдет 18-19 августа на Елагином острове в Петербурге.
3 июля 2018 16:40

Конюхов: Погружение в Марианскую впадину состоится не раньше 2021 года
Батискаф для Федора Конюхова соберут на одном из петербургских заводов. Путешественник собирается погрузиться в Марианскую впадину. Об этом он рассказал по телефону нашему телеканалу.
3 июля 2018 15:42

Полтавченко показали новейшую разработку петербургских корабелов — катамаран «Грифон»
Губернатор Санкт-Петербурга Георгий Полтавченко сегодня посетил Средне-Невский завод и осмотрел опытный образец катамарана «Грифон» проекта 23290.
2 июля 2018 17:47

Номер телефона хотят приравнять к паспорту. Эксперт рассуждает, как будет работать система
Дать телефончик какому-нибудь футбольному болельщику в баре в будущем будет не так уж безопасно. Это я так кокетливо об одной из самых обсуждаемых тем сегодня.
28 июня 2018 20:33

Ученые рассказали, чем вредны пять полезных продуктов
Полезных продуктов больше, чем вредных. Однако даже полезной еды есть та, чьи полезные свойства преувеличены.
28 июня 2018 16:07

Петербургские студенты заняли призовые места на XI Международной олимпиаде «IT-Планета 2017/18» в Тюмени
Всего же в финал вышли 30 молодых специалистов из Северной столицы. Также по результатам отборочных этапов лучшим учебным заведением стал Санкт-Петербургский государственный университет телекоммуникаций имени Бонч-Бруевича.
27 июня 2018 10:20

Абоненты Tele2 пожаловались на перебои в работе оператора
Жители Москвы, Санкт-Петербурга, Ростова-на-Дону и Екатеринбурга обратили внимание на перебои со связью в сети Tele2. О неполадках сообщает портал Downdetector.
26 июня 2018 14:18
